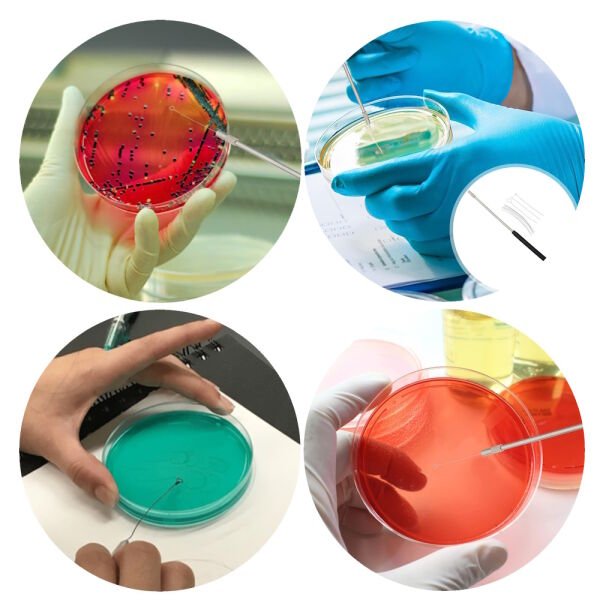
Borox Düz Öze Teli - 12 cm 0.5 mm Çap - Nikel

Borox Düz Öze Teli - 12 cm 0.5 mm Çap - Nikel
Borox Düz Öze Teli - 12 cm 0.5 mm Çap - Nikel - 10 Adet Paket - Öze Uçları ve Sapları - Alev Testlerinde Kullanıma Uygundur
Mikrobiyolojide, Bakteriyolojide, Kültür Ekimi Gibi Çok Amaçlı Kullanımlarda ve Sulu Çözeltileri Hazırlamada Kullanılır - Nikel Malzemeden Üretilmiştir
Borox Düz Öze Teli - 12 cm 0.5 mm Çap - Nikel - Ürün Kodu : S15099.512x10 - Öze Teli Uzunluk : 12 cm - Öze Teli Çap : 0.5mm
Borox S15099 for Lab Bacterial Culture Microbiology Uses - Nichrome Needle Tip Pack of 10
Ürün Kodu : S15099.512x10
Ürün Özellikleri :
- Mikrobiyolojide ve bakteriyolojide kültür ekimi gibi çok amaçlı kullanımlarda ve sulu çözeltileri hazırlamada kullanırlar.
- Metal uçlar alev testlerinde kullanıma uygundur.
- Agar yüzeyine zarar vermeden işlem olanağı sunar.
- Nikel kaplamadır.
- Özel teli uzunluğu : 12 cm , tel kalınlığı 0,5 mm dir.
- 10 adetli paket olarak cam tüp içerisinde satışa sunulur.